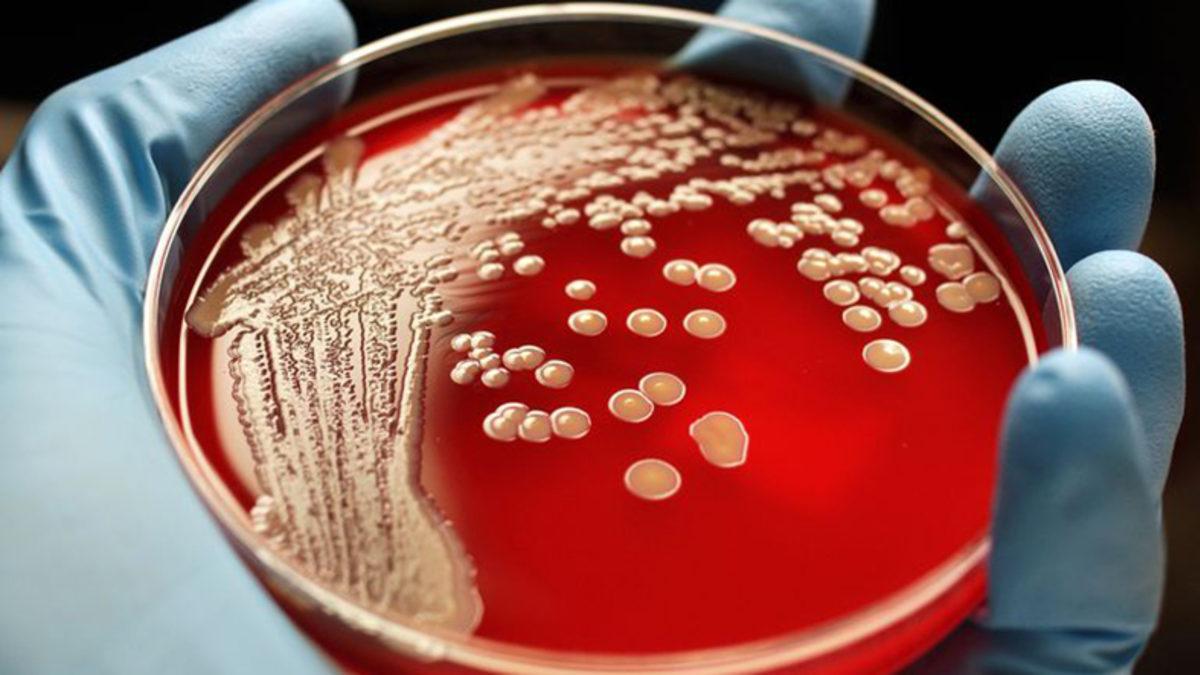
Araştırmalara Göre Bazı İnsanlar, MRSA’ya Karşı Genetik Korumaya Sahip

Bilim insanlarının yaptıkları yeni çalışma, metisiline dirençli Staphylococcus aures(MRSA) enfeksiyonlarına karşı daha iyi tedavi yöntemlerinin geliştirilmesini sağlayabilir.
Duke Üniversitesi’nin tıp bölümünde profesör olan Vance Fowler, “Antibiyotiğe dirençli staph enfeksiyonlarının görülme miktarının artması üzerine, bu tedavi edilmesi zor S.aureus enfeksiyonuna kimlerin daha duyarlı olduğunu ve neden daha duyarlı olduklarını anlamak için acil bir araştırma ihtiyacı doğdu” dedi.
Yapılan çalışmada, MRSA’lı kişilerin kan akışının enfeksiyonları çözmelerine yardımcı olduğu görünen genetik bir değişkene rastlandı.
Fowler ve ekibi, meslek, yaş, cinsiyet, sağlık koşulları ve MRSA kan dolaşımı enfeksiyonları gibi değişkenlere odaklanarak iki farklı hasta grubu oluşturdu. Araştırmacılar, 68 hastayı araştırma grupları içine aldılar. 68 kişinin yarısında kalıcı MRSA enfeksiyonu vardı. Diğer yarısı ise enfeksiyonu kan dolaşımından temizleyebilmişti.
Kanından MRSA enfeksiyonu temizlenebilen hastaların yüzde 62’sinde, kalıcı MRSA enfeksiyonu olanlarında yüzde 9’unda belirli bir genetik çeşitlilik bulundu.
Kromozom 2p’nin DNMT3A bölgesinde bulunan bu genetik mutasyon, hastanın immün tepkisinin MRSA kan dolaşımı enfeksiyonlarını daha iyi çözmesine izin veriyor gibi görünmekte.
DNMT3A mutasyonunun etkilediği görülen bağışıklık bileşenlerinden biri, konağın S.aureus enfeksiyonuna tepkisini azaltan IL-10’dur. Araştırmacılar, doğru IL-10 miktarının konak tepkisini düzenlenmesinde kritik olduğunu, IL-10’un yüksek miktarının doku hasarına, hatta ölüme sebep olduğunu ortaya çıkardı.

Gen mutasyonuna sahip olanlar arasında, serum, IL-10 seviyelerini kontrol altına aldı. Bu şekilde MRSA enfeksiyonunun daha iyi temizlenebildiğini araştırmacılara gösterdi.
Vance Fowler, “Çalışmamız, MRSA enfeksiyonlarını çözme yeteneğinin artmasına katkıda bulunan DNMT3A mutasyonunu ortaya çıkarmaktadır.” dedi.